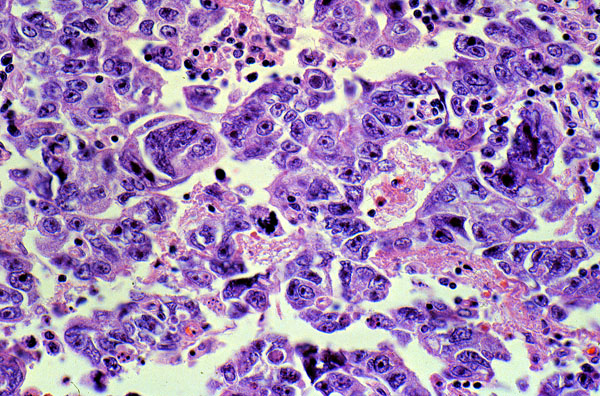

Embryonal carcinoma, histology, high power
Click picture to enlarge. Close window to return
The tumor is composed of loosely arranged cells that form solid nests and abortive papillary structures. The cell outlines are indistinct and the nuclei are frequently overlapping.